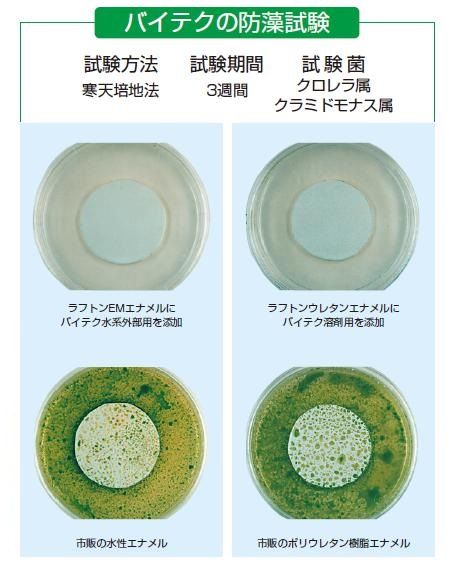
バイテク藻08

防かび・防藻剤【バイテク】のご紹介|福岡で塗装ならトラストホーム
2015.09.08更新
目 次
こんにちは。福岡の塗装専門店トラストホームです。
今回は、【バイテク】を紹介します!
目次
塗料用防かび・防藻剤【バイテク】のご紹介です。
★温暖で多湿な日本の風土は、カビや藻類の生育に適しています。このため、我が国の生活様式は、古くからカビやその他の微生物と、深い関わりを持ってきました。酒・みそ・醤油などの発酵技術は、カビとの付き合いから生まれた、我が国の代表的な生活の知恵といえます。また、開放的な構造を持つ日本家屋は、梅雨時期のじめじめを防ぎ、住居をカビから守ってきました。
★しかし、近年になり建物のコンクリート化、新建材・アルミサッシなどの普及によって建物の高気密化が進み、湿害が深刻になってきました。湿害は、結露およびカビの発生に始まり、建物内外装材の汚染・劣化を引き起こし、さらには喘息・アレルギーなどの居住者の健康にも障害をもたらします。この他、造成地に建てられた住宅の外壁では、藻類発生による緑化汚染が問題となっています。
★バイテクは、現場で各種塗料へ簡単に混入でき、塗膜に優れた防カビ・防藻性を付与します。
バイテクは、強力な防カビ・防藻性付与剤です。
バイテクには、すぐに使える現場混入方式です。
バイテクには、タイプがあります。